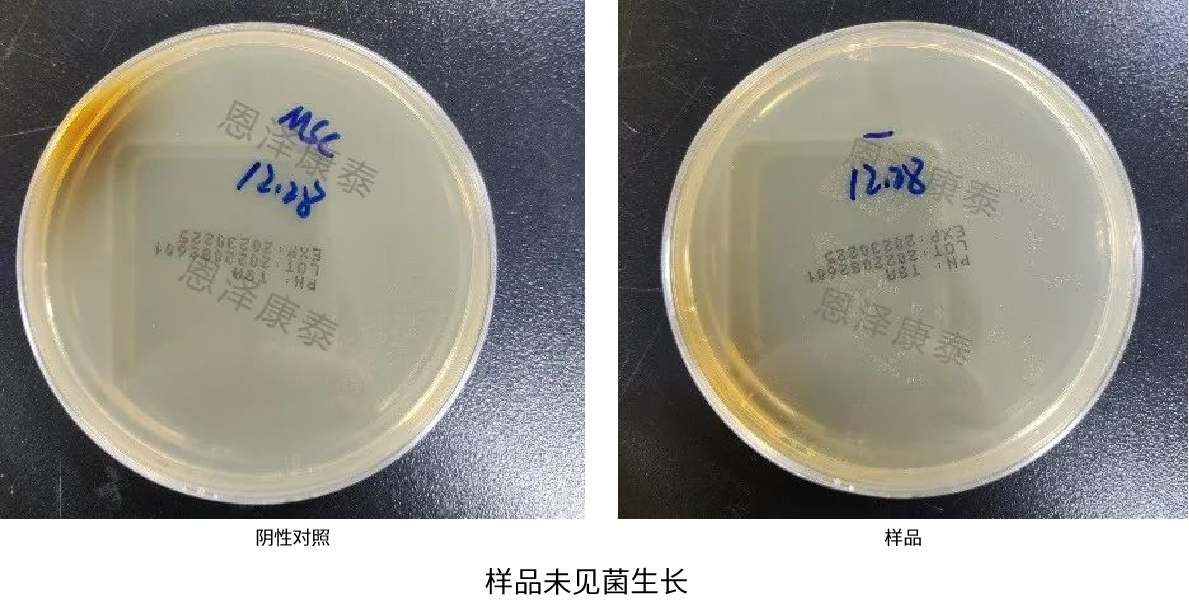

粒径:以二氧化硅硅纳米颗粒为标准品,利用一系列粒径已知(经 TEM 表征)的二氧化硅纳米颗粒的混合物,建立散射光强度与颗粒粒径的标准工作曲线,即可将同等采样条件下EV的散射光强度转换为颗粒粒径。
浓度:通过检测特定时间内已标定浓度的荧光微球的个数,快速得到特定进样压力下样品流的体积流量,即可得到在相同进样压力条件下待测样品的颗粒浓度。
纳米流式仪

基于双缩脲原理,碱性条件下蛋白质将Cu2+还原成Cu+,BCA(二喹啉甲酸)鳌合Cu+作为显色剂,产生蓝紫色并在562nm有吸收峰,单价Cu+与蛋白质呈剂量相关性。可以根据待测蛋白在562nm处的吸光度,与标准曲线对比,便可计算待测蛋白浓度。
BCA定量试剂盒

经加速和聚集的电子束透射到预制备的非常薄的外泌体样品上,电子与样品中的原子碰撞而改变方向产生立体角散射。散射角的大小与样品的密度、厚度等相关,因此可以形成明暗不同的影像,经放大、聚焦后在荧光屏上显示出外泌体的影像。
透射电子显微镜(Transmission Electron Microscope, 简称TEM)

在样品的两端加一个电场,导致颗粒加速运动,散射的激光因为颗粒运动而产生频率变化(多普勒效应),散射的激光和原始光源之间的相干产生一个调制的信号,分析频率变化可以计算电泳迁移率,通过Henry方程计算粒子在该体系中所带的电荷情况(Zeta电位),-500mV-500mV。
动态光散射粒度测定仪

通过抗体对凝胶电泳处理过的外泌体样本进行特异性结合,并通过HRP标记的二抗级联放大检测信号,经过底物化学发光试剂(如ECL)发光以检测电泳分离的特异性目的基因表达的蛋白成分。
免疫印迹法,Western Blot,WB

用于检查药典要求无菌的药品、医疗器具、原料、辅料及其他品种是否无菌的一种方法,无菌检查是通过目检微生物在培养基中的生长来判断结果,若供试品符合无菌检查法的规定,仅表明供试品在该检验条件下未发现被微生物污染。
培养基培养法
若外泌体被支原体污染,支原体DNA的保守序列会被大量、快速地扩增,使反应液由蓝紫色变成天蓝色,结果肉眼可辨,可以对常见的8种支原体进行快速检测。
试剂盒法

Triton-100具有破膜功能,可对有膜颗粒如外泌体进行裂解,而对无膜颗粒无影响,通过Triton-100裂解后便可检测外泌体样品中有膜颗粒占比,是外泌体纯度的另一种反映。
纳米流式检测裂解前后的颗粒

外泌体上有CD81/CD63/CD9标签蛋白,分别使用荧光标记的CD81/CD63/CD9抗体与外泌体一起孵育结合后会产生较强荧光,纳米流式仪能够完全区分散射光和荧光,进而检测出带有CD81/CD63/CD9蛋白的外泌体颗粒阳性占比。从而反映出外泌体的纯度,或不同来源/不同纯化方式/特殊处理下的外泌体的表面标志蛋白阳性占比。
纳米流式

外泌体上的目的蛋白连接有FLAG等标签,使用荧光标记的FLAG等抗体与外泌体孵育结合后会产生较强荧光,纳米流式仪器能够完全区分散射光和荧光,进而检测出带有目的蛋白的外泌体颗粒阳性占比。这种定量方式一方面可以反应外泌体蛋白表面工程化的效率,从单颗粒水平评估的结果更准确。另一方面跟WB定性检测互为补充。此外也可避免繁琐的不同蛋白WB检测时的抗体测试优化。
纳米流式

外泌体:在特定波长下有特征荧光信号,外泌体包裹的蛋白和核酸在紫外280nm和紫外260nm下有弱吸收峰,在特定保留时间下出峰
蛋白:紫外280nm下有峰
核酸:紫外260nm下出峰
SEC色谱柱后连接HPLC,便可在不同检测器下检测外泌体、蛋白和核酸杂质的峰图,进而考察外泌体的纯度指标
HPLC
